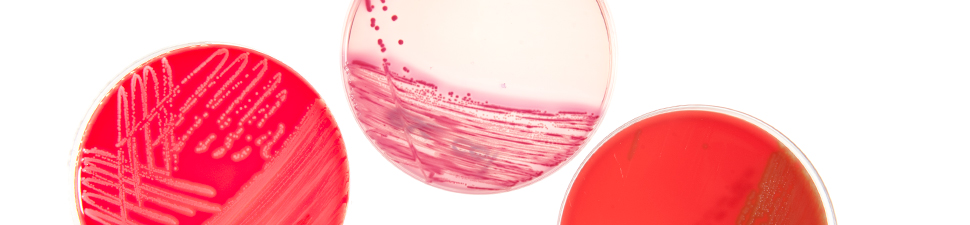

Le Département de médecine et le Département médecine de laboratoire et pathologie ont le plaisir de vous inviter à la Journée de la recherche. Voici…
"Nous sommes heureux de vous présenter nos activités. Que vous soyez patient, étudiant, chercheur ou collaborateur du domaine de la santé, nous sommes à disposition pour répondre à vos questions."
Plus de 120 collaborateurs travaillent dans notre service.
L’équipe clinique comprend des spécialistes de renommée internationale dont les vastes connaissances permettent d’appréhender les situations d’infectiologie générale (consultations ambulatoires et consultations hospitalières) ou celles qui relèvent de domaines hautement spécialisés :
L'équipe de recherche est constituée de plusieurs groupes de recherche composés de scientifiques (biologistes et médecins) de haut niveau travaillant dans les domaines de la recherche fondamentale, translationnelle et clinique. Cette activité a pour but d'approfondir les connaissances de base des maladies infectieuses, ceci pour améliorer le diagnostic, la prévention et le traitement des infections survenant dans la population en général ou chez des patient-e-s présentant des facteurs de risques particuliers. Les différents groupes de recherche du service ont acquis une renommée internationale et leurs travaux ont été récompensés par de nombreux prix au plan national et international.
Le service est également très engagé dans l'enseignement pré-gradué et post-gradué de la microbiologie, de l'immunologie et des maladies infectieuses destiné aux étudiants de la Faculté de Biologie et de Médecine de l'Université de Lausanne, ainsi qu'aux médecins en formation et aux professionnels de la santé.
Notre Service fait partie du Département de médecine du CHUV.
Le Département de médecine et le Département médecine de laboratoire et pathologie ont le plaisir de vous inviter à la Journée de la recherche. Voici…
Nous avons le plaisir d’annoncer la nomination du Dr David Martin en tant que Médecin associé au sein de notre service.